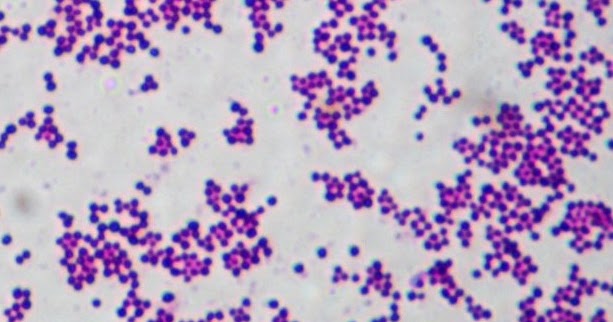
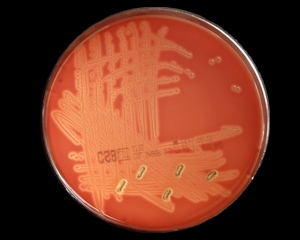
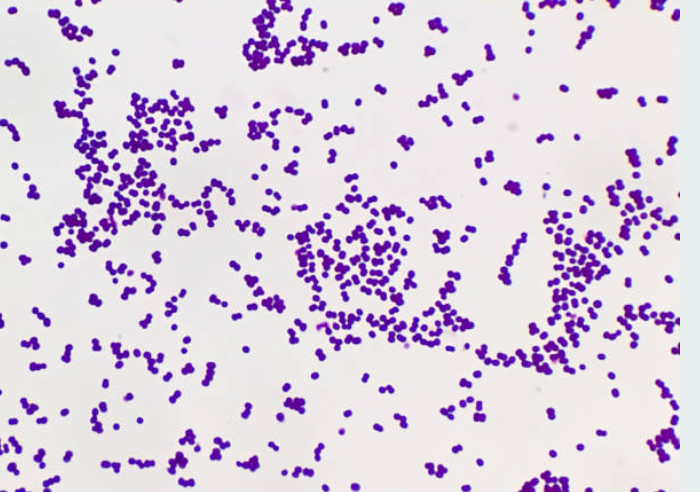

Staphylococcus agalactiae
Сборка душевой кабины sw
Одежда для школы для подростков 2025 мальчик
Северную корею затопило
Компании страхования осаго
Моя жизнь мирок
Клубника хони описание сорта
Если я влюбилась в мальчика
Цветовая гамма в школе
Болиголов настойка от рака инструкция по применению
Китайский животный цикл
Жим лежа суровецкий
Вино tresors
Белое в уголках глаз что это
Staphylococcus agalactiae 110 фото